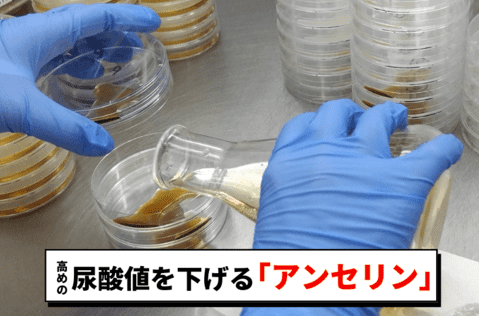

年齢を重ねるごとに
肥満体型
になっていませんか?
飲み会もあるし
家でもよく晩酌してるし
不摂生のツケが回ってきた…
「若い頃は痩せていたのに…」
体重は記録更新の連続。
医者や家族からも指摘され…

ビールはプリン体も高いから
ついに“尿酸値”が
健康診断で引っかかりました…

このままだと、
ウワサに聞く激痛
“アレ”にもなっちゃいそう

軽いジョギングもして
少しは体重落ちたけど…

何やっても痩せられないし

…って思ってたとき、
読売新聞に載ってたコレ!

「NHKで特集された成分配合」
脂肪×尿酸値にWで効く
酒飲みにピッタリの対策!

こんなぽっこりお腹が

無理な食事制限・運動もナシに
すっきりした
お腹周りに!!
ビールやごはんは我慢せず
健康的な理想体型に!
![]()
実際に使い始めて
こんなに変化があった人も!

実はコレ・・・
NHK出演医師が監修
しているホンモノ!
科学的根拠が認められて
クリニックでも
取り扱いされてるんです!

さらに、、、
楽天ランキングで3冠達成!

それがこの…
\日本初のW効果サプリ/
– W BUSTER –
ダブルバスター

普通のサプリと違って、
日本で初めて受理された
『脂肪×尿酸』W効果の
機能性表示食品なんです!
![]()

実際の臨床試験でも
脂肪減少効果が実証!
そして、あの
「出て来いやァ!」
でお馴染みの
髙田延彦さんも愛用!

でも、、、
「普通のサプリと何が違うの?」
「どうしてそんなに痩せるの?」

ダブルバスターが
“本当に脂肪に効く”
理由はコチラ!


下半身は普通でも
“お腹周りが太っている”のは
典型的な内臓脂肪の肥満

この、内臓脂肪型の人は
普通のダイエットだと落ちないから
リバウンドしやすいんです。

脂肪を減らすだけの商品は
たくさんありますよね。

実は…!!
内臓脂肪と尿酸値は
密接な関係があるんです。

何故なら、
普通のダイエットでは
尿酸値は下がらない。

両方セットで落とさないと
全く意味がないんです!

この2つとも同時に落とす
というのがとても厄介…
でもダブルバスターなら!
脂肪と尿酸値にWで効くから
特に、、、

って人にピッタリ!!

メカニズムはわかった。
ダブルバスターは
本当に効くの???
という方…

「皮下脂肪・内臓脂肪を減らす」と
専門家を中心に業界に激震を走らせた
『ブラックジンジャー』を配合。

その働きは凄まじく…!

体内で脂肪を分解して
消費してくれるんです!

実は今、
医学界でも大注目の成分で
医学誌にも掲載されるほど!

そして大事なのは
尿酸値も下がるのかどうか。
東京大学が研究に関わった
高い尿酸値を下げる成分
『アンセリン』を独自配合!
アンセリンはNHKでも紹介され
“日本初”の量産化
に成功した特許成分
尿酸の生産抑制&排泄促進
2つの働きがあるんです!

まさに酒飲みのための
尿酸対策成分!
ダブルバスターの凄いところ。
「脂肪」と「尿酸」の
W効果が認められたのは日本初!
しかも、消費者庁が受理した
機能性表示食品だから
普通のサプリとは訳が違うんです。


早速ネットで注文。
すぐに届きました!
中身はこんな感じ。

お酒や食事は普段通り
1日3粒を毎日飲んでみました!

そして、続けていると…
1袋目の終わりかけには、
お腹周りの脂肪が減っているッ!

ちなみに検証なので、
筋トレは一切していません。
体重も測定してみると…

これは期待できるかも…!
そして、
健康診断の結果が届くと…

マジか…!
A判定(良好)になってました!🔥

このダブルバスター、
さすがの効き目と信頼度なので
通常価格は、1袋30日分
7,980円(税込)とちょっとお高め…
でもここからの公式サイト限定!!
初回500円(税込)で試せる
アンケートキャンペーン中!

なんと通常価格から
7,480円も安い大特価!
しかも、超安心。
安いからと言って
定期お届け回数に縛りは
一切ありません。

公式サイトにも
しっかり記載されているので安心!

しかも、
絶対に公式サイトで買うべき理由は
365日の返金保証付きだから!

もし実感できなかったら全額返金!
つまり、リスクはほぼ無し!
支払い方法もクレカ以外に
安心のコンビニ後払いOK!

今月の在庫が無くなる前に
下のアンケートに答えて
500円でGETしてください!









※緊急更新※
500円のお試しモニターは
予想以上の反響があるようで
いつ終わってしまうか分かりません。

1日あたり16円で
試せるのもこの記事から飛べる
公式サイトだけ…!!
Amazon・楽天でも
ほぼ通常価格でした😭

しかも、公式サイトなら
365日にも及ぶ長期間
返金保証付き!!

リスクがない今のうちに
500円でGETしてください!

